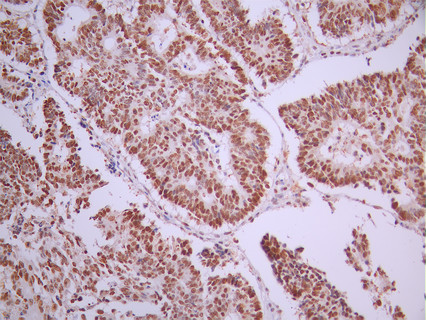

MSH6 Recombinant Monoclonal Antibody
-
中文名稱:MSH6 Recombinant Monoclonal Antibody
-
貨號:CSB-RA091472A0HU
-
規格:¥1320
-
圖片:
-
IHC image of CSB-RA091472A0HU diluted at 1:100 and staining in paraffin-embedded human colorectal cancer performed on a Leica BondTM system. After dewaxing and hydration, antigen retrieval was mediated by high pressure in a citrate buffer (pH 6.0). Section was blocked with 10% normal goat serum 30min at RT. Then primary antibody (1% BSA) was incubated at 4°C overnight. The primary is detected by a Goat anti-rabbit polymer IgG labeled by HRP and visualized using 0.05% DAB.
-
Immunofluorescence staining of Hela cell with CSB-RA091472A0HU at 1:50 , counter-stained with DAPI. The cells were fixed in 4% formaldehyde, permeabilized using 0.2% Triton X-100 and blocked in 10% normal Goat Serum. The cells were then incubated with the antibody overnight at 4°C. The secondary antibody was Alexa Fluor 488-congugated AffiniPure Goat Anti-Rabbit IgG(H+L).
-
Overlay Peak curve showing Hela cells stained with CSB-RA091472A0HU (red line) at 1:100. The cells were fixed in 4% formaldehyde and permeated by 0.2% TritonX-100 for 10min. Then 10% normal goat serum to block non-specific protein-protein interactions followed by the antibody (1ug/1*106cells) for 45min at 4℃. The secondary antibody used was FITC-conjugated goat anti-rabbit IgG (H+L) at 1/200 dilution for 35min at 4℃.Control antibody (green line) was Rabbit IgG (1ug/1*106cells) used under the same conditions. Acquisition of >10, 000 events was performed.
-
-
其他:
產品詳情
-
Uniprot No.:
-
基因名:
-
別名:DNA mismatch repair protein Msh6 antibody; G/T mismatch binding protein antibody; G/T mismatch-binding protein antibody; GTBP antibody; GTMBP antibody; hMSH6 antibody; HNPCC 5 antibody; HNPCC5 antibody; HSAP antibody; MSH 6 antibody; MSH6 antibody; MSH6_HUMAN antibody; mutS (E. coli) homolog 6 antibody; MutS alpha 160 kDa subunit antibody; MutS homolog 6 (E. coli) antibody; mutS homolog 6 antibody; MutS-alpha 160 kDa subunit antibody; p160 antibody; Sperm associated protein antibody
-
反應種屬:Human
-
免疫原:A synthesized peptide from human MSH6 protein
-
免疫原種屬:Homo sapiens (Human)
-
標記方式:Non-conjugated
-
克隆類型:Monoclonal
-
抗體亞型:Rabbit IgG
-
純化方式:Affinity-chromatography
-
克隆號:22F3
-
濃度:It differs from different batches. Please contact us to confirm it.
-
保存緩沖液:Rabbit IgG in 10mM phosphate buffered saline , pH 7.4, 150mM sodium chloride, 0.05% BSA, 0.02% sodium azide and 50% glycerol.
-
產品提供形式:Liquid
-
應用范圍:ELISA, IHC, IF, FC
-
推薦稀釋比:
Application Recommended Dilution IHC 1:50-1:200 IF 1:50-1:200 FC 1:50-1:200 -
Protocols:
-
儲存條件:Upon receipt, store at -20°C or -80°C. Avoid repeated freeze.
-
貨期:Basically, we can dispatch the products out in 1-3 working days after receiving your orders. Delivery time maybe differs from different purchasing way or location, please kindly consult your local distributors for specific delivery time.
-
用途:For Research Use Only. Not for use in diagnostic or therapeutic procedures.
相關產品
靶點詳情
-
功能:Component of the post-replicative DNA mismatch repair system (MMR). Heterodimerizes with MSH2 to form MutS alpha, which binds to DNA mismatches thereby initiating DNA repair. When bound, MutS alpha bends the DNA helix and shields approximately 20 base pairs, and recognizes single base mismatches and dinucleotide insertion-deletion loops (IDL) in the DNA. After mismatch binding, forms a ternary complex with the MutL alpha heterodimer, which is thought to be responsible for directing the downstream MMR events, including strand discrimination, excision, and resynthesis. ATP binding and hydrolysis play a pivotal role in mismatch repair functions. The ATPase activity associated with MutS alpha regulates binding similar to a molecular switch: mismatched DNA provokes ADP-->ATP exchange, resulting in a discernible conformational transition that converts MutS alpha into a sliding clamp capable of hydrolysis-independent diffusion along the DNA backbone. This transition is crucial for mismatch repair. MutS alpha may also play a role in DNA homologous recombination repair. Recruited on chromatin in G1 and early S phase via its PWWP domain that specifically binds trimethylated 'Lys-36' of histone H3 (H3K36me3): early recruitment to chromatin to be replicated allowing a quick identification of mismatch repair to initiate the DNA mismatch repair reaction.
-
基因功能參考文獻:
- discover a translocation disrupting MLH1 and three mutations in MSH6 and PMS2 that increase endometrial, colorectal, brain and ovarian cancer risk PMID: 28466842
- Whole exome sequencing in triple negative breast cancer cases revealed MSH6 rs2020912 (MAF: 56.25% vs. 1.04%, OR 122.13, 95% CI 12.29-2985.48) are risk factors for triple negative breast cancer. PMID: 30136158
- CSE1L expression was correlated with MSH6 expression in tumor samples and was associated with poor prognosis in patients with osteosarcoma. Taken together, our results demonstrate that the CSE1L-MSH6 axis has an important role in osteosarcoma progression. PMID: 28387323
- our data suggests thatMSH6 Glu39Gly polymorphism is associated with the risk of developing sporadic colorectal cancer in polish population. Linkage to the female gender, onset above 60 years old and further increase of risk when combined with wild-type allele of PMS2 IVS1-1121C > PMID: 28451866
- Results from a study on gene expression variability markers in early-stage human embryos shows that is a putative expression variability marker for the 3-day, 8-cell embryo stage. PMID: 26288249
- hMSH6 Glu39Gly polymorphism is associated with the risk of developing colorectal cancer in the Polish population. PMID: 29442465
- Expression of MSH6 and MSH2 was positively associated with tumor volume doubling time. Gene expression was positively associated with ATR expression. Reduction of MSH6 and MSH2 expression at the messenger RNA and protein levels could be involved in direct Pituitary Adenoma proliferation by promoting cell-cycle progression or decreasing the rate of apoptosis through interference with the function of the ATR-Chk1 pathway. PMID: 29342268
- Our results suggest that increased expression of MSH6, or other MMR, may be a new mechanism contributing to the acquired resistance during TMZ therapy; and may serve as an indicator to the resistance in GBM. PMID: 29366782
- study to estimate frequency of point mutations and chromosomal rearrangements in 3 mismatch repair (MMR) genes MLH1, MSH2, and MSH6 among unselected patients with ovarian cancer; estimate that approximately 0.6% of unselected ovarian cancer patients have mutations in the MMR genes PMID: 28176205
- MSH6 frameshift variants incompletely segregate with the Lynch syndrome phenotype in two families. PMID: 28481244
- Patients with mutations 6 showed higher rate of achieving major molecular response than those<6 (P=0.0381). Mutations in epigenetic regulator, ASXL1, TET2, TET3, KDM1A and MSH6 were found in 25% of patients. TET2 or TET3, AKT1 and RUNX1 were mutated in one patient each. ASXL1 was mutated within exon 12 in three cases PMID: 28452984
- The MSH6 gene polymorphisms are likely to play an important role in the progression of AIDS in the northern Chinese population. PMID: 27090025
- MSH6 mutations contribute to colorectal cancer susceptibility in Algerian families with suspected Lynch syndrome. PMID: 27468915
- Neoadjuvant therapy in microsatellite-stable colorectal carcinoma induces concomitant loss of MSH6 and Ki-67 expression. PMID: 28232158
- High MSH6 expression is associated with the development of genetic instability and is linked to tumor aggressiveness and early PSA recurrence in prostate cancer. PMID: 27803051
- In path_MSH6 10-year survival was 84%, relative incidence of subsequent cancer compared with incidence of first cancer was slightly but insignificantly higher than cancer incidence in patients with Lynch syndrome without previous cancer. PMID: 27261338
- human Pol alpha interacts with MSH2-MSH6 complex PMID: 27805738
- In colorectal neoplasms, negative expression of the MMR proteins MLH1, MSH2 or MSH6 was seen in 15% (47 of 313) of the patients. Defect MLH1 was most common and detected in 12% of the cases. Defect MLH1 and MSH2 were identified in each patient's normal adjacent mucosa. PMID: 27836416
- A total of 201 unique disease-predisposing mismatch repair gene mutations were identified in 369 Lynch syndrome families. These mutations affected MLH1 in 40%, MSH2 in 36%, MSH6 in 18% and PMS2 in 6% of the families PMID: 27601186
- There is a positive correlation between the expressions of hMSH2 and hMSH6 between males (RHO=0.673 and p=0.001) and females with colorectal adenocarcinoma. PMID: 27459116
- Individuals with Lynch syndrome and double-mutants in MSH6 and MSH2 had normal MSH2 expression, whereas MSH6 immunoexpression was lost in all evaluable cases. PMID: 26446363
- we identified gene promoter methylation signatures (WT1, MSH6, GATA5 and PAX5) that are strongly correlated to, and can have a predictive value for the clinical outcome of oral squamous cell carcinoma patients PMID: 27491556
- In Lynch syndrome families, prostate cancer was associated with mutations in MSH6 with loss of the mismatch repair protein. PMID: 27013479
- Loss of MSH-2/MSH-6 expression was correlated with the right-colon location, poor and mucinous differentiation in colorectal adenocarcinoma. PMID: 26097592
- Heterozygous germline mutations in any of the mismatch repair (MMR) genes, MLH1, MSH2, MSH6, and PMS2, cause Lynch syndrome (LS), an autosomal dominant cancer predisposition syndrome. PMID: 26544533
- MSH2, MSH6, and EXO1 genes were overexpressed in gastroesophageal cancers. PMID: 26215063
- SNP rs1800934 and 12 rare variants in the mismatch repair gene MSH6 were also associated with cafe-au-lait macule count in neurofibromatosis type 1 patients. PMID: 25329635
- microsatellite instability-high and loss of MSH6 were found. Based on these results, genetic testing of MSH6 revealed a frame-shift mutation in codon 604 PMID: 26805314
- MutSalpha, proliferating cell nuclear antigen, and replication factor C activate MutLalpha endonuclease to remove the 1-nucleotide Okazaki fragment flaps PMID: 26224637
- We describe a kindred with multiple gastrointestinal malignancies where a novel MSH6 germline susceptibility variant was identified PMID: 25380764
- Heterogenous MSH6 loss is uncommon, usually caused by instability in MSH6 exon 5 polycytosine tract, and not associated with germline MSH6 mutation. PMID: 26099011
- immunohistochemical expression of MLH1, MSH2, and MSH6 in initial glioblastoma is not associated with patient survival PMID: 24995467
- The study evaluates the frequency and distribution of mutations in the MLH1, MSH2 and MSH6 genes within a cohort of families with Lynch syndrome in Cyprus. PMID: 25133505
- Somatic rearrangements in MSH2 and MSH6 are an important mechanism leading to hypermutation and microsatellite instability in advanced prostate cancer. PMID: 25255306
- Our database and literature searches retrieved 30 MLH1, 22 MSH2, 4 MSH6 and 9 PMS2 alternative transcripts, many predicted to introduce premature termination codons PMID: 24989436
- After a short turnaround time of less than 3 weeks, the diagnosis of CMMR-D could be confirmed by the identification of a homozygous 29-bp deletion in MSH6 (exon 6), which was confirmed by independent methods. PMID: 25431869
- We identified 11 previously unreported mutations in MSH6 in nine different glioma samples and in three oligodendrogliomas and two treatment-naive gliomas PMID: 25078279
- MSH6 founder mutations in Ashkenazi Jews with Lynch syndrome PMID: 23990280
- Some uterine carcinosarcomas show loss of MSH6. PMID: 25083964
- When controlling for surgical and pathologic factors, mismatch repair protein expression did not predict lymph node yield after colectomy for Colon cancer . PMID: 25664706
- The survival time of patients with osteosarcoma may be predicted by local expression of MSH6 and MSH2/6 in surgical primary tumor resections. PMID: 25503122
- isolated loss of expression of hMSH6 in the basal cell layer of oral carcinoma in situ lesions could potentially be a useful diagnostic biomarker for these lesions PMID: 25352643
- Results show that MSH6 and MSH2 expressions are downregulated by YB-1. PMID: 24141788
- DNA mismatch repair gene MSH6 implicated in determining age at natural menopause. PMID: 24357391
- We here demonstrate the causative role of the first germline mutation of MSH2, c.1249-1251 dupGTT (p.417V-418I dupV), associated with normal hMSH2 expression and lack of hMSH6 protein despite a normal MSH6 gene sequence PMID: 25106712
- Immunohistochemistry revealed loss of expression for MLH1, MSH2, MSH6, and PMS2 in 15, 21, 13, and 15 % of cases, respectively...we found a perfect association between MMR immunohistochemical analyses and MSI molecular investigation PMID: 24643686
- This report specifically focus on the protein expression profile and germline mutations of MSH6 and PMS2 genes in 50 Malaysian Lynch syndrome suspected patients. PMID: 24072394
- identified some statistical evidence for an association between the MSH6 G39E polymorphism and risk of cancer PMID: 24622885
- MSH6 protein expression can be a valuable marker to improve prognosis assessment in primary melanoma. PMID: 24926095
- three MSH6 variants found in suspected Lynch syndrome families, MSH6-P1087R, MSH6-R1095H and MSH6-L1354Q were found not to be disease causing when expressed in a mouse model PMID: 24040339
顯示更多
收起更多
-
相關疾病:Hereditary non-polyposis colorectal cancer 5 (HNPCC5); Endometrial cancer (ENDMC); Mismatch repair cancer syndrome (MMRCS); Colorectal cancer (CRC)
-
亞細胞定位:Nucleus. Chromosome. Note=Associates with H3K36me3 via its PWWP domain.
-
蛋白家族:DNA mismatch repair MutS family
-
數據庫鏈接:
Most popular with customers
-
-
YWHAB Recombinant Monoclonal Antibody
Applications: ELISA, WB, IHC, IF, FC
Species Reactivity: Human, Mouse, Rat
-
Phospho-YAP1 (S127) Recombinant Monoclonal Antibody
Applications: ELISA, WB, IHC
Species Reactivity: Human
-
-
-
-
-